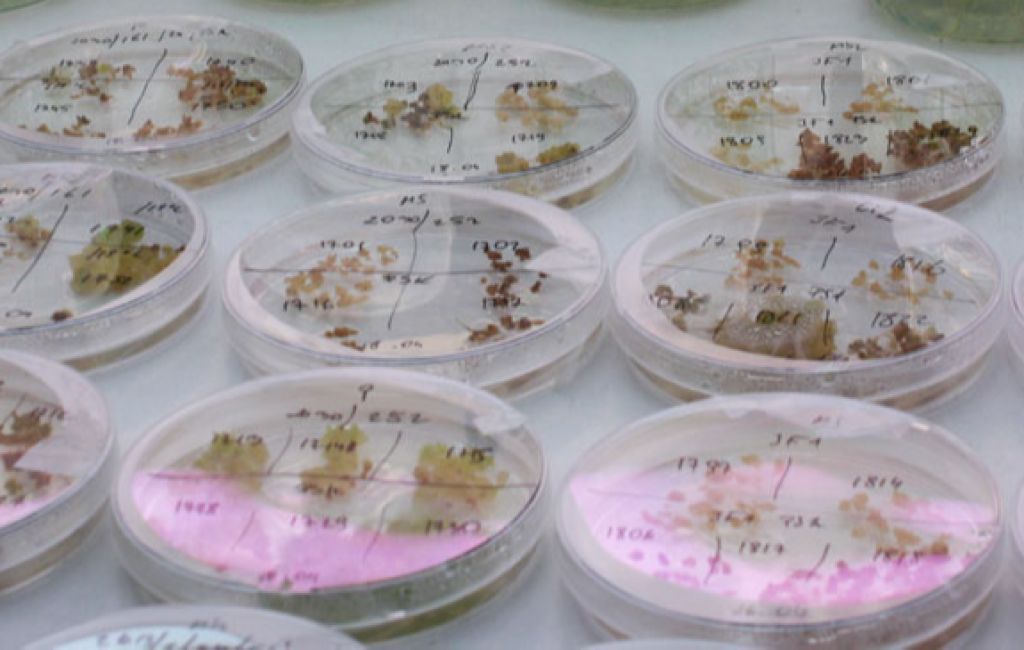
Studia Kraków - Uniwersytet Rolniczy im. Hugona Kołłątaja w Krakowie

Terminy rekrutacji na studia Drzwi otwarte na uczelniach Terminy matury Terminy egzaminu ósmoklasisty
12.07.2023
I etap rekrutacji 2023/2024 na URK potrwa do 12 lipca 2023 r.
Bioinżyneiria zwierząt, food engineering, a może leśnictwo?
Harmonogram rekrutacji na URK na rok 2023/2024
Internetowa Rekrutacja Kandydatów
Uniwersytet Rolniczy im. Hugony Kołłątaja w Krakowie jest publiczną uczelnią akademicką prowadzącą specjalistyczną działalność badawczą i dydaktyczną obejmującą dziedziny rolnictwa, żywienia, leśnictwa i ochrony środowiska oraz rozwoju we wszystkich dziedzinach swojej działalności, tj.: przyrodniczej, technicznej, społecznej i ekonomicznej. Uczelnia przyczynia się do tworzenia innowacji, które sprzyjają osiągnięciu bezpieczeństwa żywnościowego i neutralności klimatycznej, zwiększają konkurencyjność gospodarki opartej na materiałach i procesach biologicznych oraz umożliwiają reagowanie na wyzwania społeczne i cywilizacyjne.
dowiedz się więcej:
Rekrutacja na studia 2026 w Krakowie
Uniwersytet Rolniczy w Krakowie (URK) - rekrutacja na studia 2026/2027
https://rekrutacja.urk.edu.pl/











